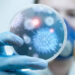
Salgın paniği! Kaynağı tespit edilemedi, vaka sayısı hızla artıyor

Ankara’da öldürülen eski Ülkü Ocakları Genel Başkanı Sinan Ateş’in eşi Ayşe Ateş, MHP Genel Sekreteri İsmet Büyükataman’ın Sinan Ateş’in öldürüleceğini bildiği halde suikastı önlemek için hiçbir tedbir almadığını iddia etti. Ayşe Ateş, ‘‘Evladım” dediğin insanın…sokak ortasında katledilmesini çekirdek çitleyerek izlediğin, katledildikten sonra, sana ‘dede’ diyen kızlarımın göz yaşlarına kıs kıs güldüğün bir siyasi cinayet.’’ ifadelerini kullandı.
MHP Genel Sekreteri İsmet Büyükataman, sosyal medya hesabından MHP Genel Başkanı Devlet Bahçeli’nin “Yargıya intikal etmiş bir cinayet davasında partimizin ve Ülkü Ocakları’nın suçlanması, hatta dahilde ve hariçte Ülkü Ocakları’na suç örgütü gölgesi düşürmek için kolları sıvayan ajan ve provokatörlerin sırtının sıvazlanması tesadüf değildir. Hepsini biliyoruz, hepsini takip ediyoruz, verilmeyecek bir hesabımızın olmadığını cümle alemle paylaşıyoruz.” sözlerini paylaştı.
MHP Genel Sekreteri İsmet Büyükataman, Sinan Ateş’in ölümünü “yargıya intikal etmiş cinayet davası” olarak tanımlamasına Sinan Ateş’in eşi Ayşe Ateş tepki gösterdi. Büyükataman’ın paylaşımını alıntılayan Ateş X hesabından yaptığı paylaşımda şu ifadeleri kullandı:
“Ey İsmet Büyükataman!
Ey makam sahibi muhterem kişi!
İnsandan vefa dilenen bu yüzyılın
Koltuğuyla insanlığını çiğneyen hiçi
Yaptığın paylaşım izaha muhtaç. Gel,düzeltelim.
Yargıya intikal etmiş bir cinayet davası değil. “Evladım” dediğin insanın -öldürüleceğini bildiğin hâlde- canice öldürülmesini önlemek için hiçbir girişimde bulunmadığın, sokak ortasında katledilmesini çekirdek çitleyerek izlediğin, katledildikten sonra, sana “dede” diyen kızlarımın göz yaşlarına kıs kıs güldüğün bir siyasi cinayet. Tutuklu bulunanların ve cinayet şüphelisi sıfatıyla hakkında soruşturma yürütülenlerin büyük çoğunluğunun Ülkü Ocakları ve MHP mensubu olduğu bir siyasi cinayet.
Dedim ya: Paylaşımın izaha muhtaç.’’
Ey İsmet Büyükataman!
Ey makam sahibi muhterem kişi!
İnsandan vefa dilenen bu yüzyılın
Koltuğuyla insanlığını çiğneyen hiçi
Yaptığın paylaşım izaha muhtaç. Gel,düzeltelim.
Yargıya intikal etmiş bir cinayet davası değil. “Evladım” dediğin insanın -öldürüleceğini bildiğin hâlde-… https://t.co/Bf0Au3at1Z
— Ayşe Ateş (@ayseatesaa) June 5, 2024
Türkiye’de bu haberi engelsiz paylaşmak için aşağıdaki linki kopyalayınız👇
Kaynak: Tr724
***Mutluluk, adalet, özgürlük, hukuk, insanlık ve sevgi paylaştıkça artar***




![Tr724 [Haber Merkezi]](https://serbestgorus.com/wp-content/uploads/2026/06/AKP-ara-secimlerde-moral-buldu-6-beldede-5-belediyeyi-Cumhur-360x180.jpg)


























![Tr724 [Haber Merkezi]](https://serbestgorus.com/wp-content/uploads/2026/06/AKP-ara-secimlerde-moral-buldu-6-beldede-5-belediyeyi-Cumhur-350x250.jpg)